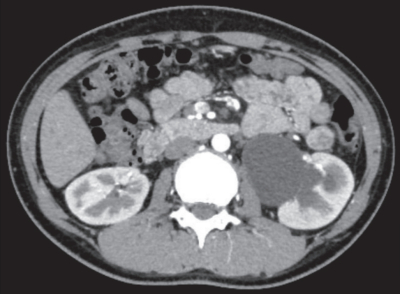
#

12 歳の女児。1 週間前から断続的に生じる左側腹部痛を主訴に来院した。既往歴に特記すべきことはない。
身長 153 cm、体重 42 kg。 体温 36.3 ℃。脈拍80/分、整。血圧 112/72 mmHg。呼吸数 12/分。腹部は平坦で、反跳痛を認めない。左の肋骨脊柱角に叩打痛を認める。尿所見:蛋白(-)、糖(-)、ケトン体(-)、潜血(-)、沈渣に異常を認めない。
血液所見:赤血球 474 万、Hb 13.0 g/dL、Ht 40 %、白血球 6,500、血小板 28 万。血液生化学所見:総蛋白 6.7 g/dL、アルブミン 4.3 g/dL、総ビリルビン 0.3 mg/dL、AST 14 U/L、ALT 8 U/L、LD 156 U/L(基準 120~245)、尿素窒素 9 mg/dL、クレアチニン 0.5 mg/dL、尿酸3.5 mg/dL、 血 糖 82 mg/dL、Na 144 mEq/L、K 4.0 mEq/L、Cl 108 mEq/L、Ca 8.8 mg/dL。腹部単純 CT で尿路に石灰化陰影や走行異常を認めない。腹部造影 CT 水平断像、造影 CT 後の腹部エックス線写真及び利尿レノグラムを別に示す。
治療として適切なのはどれか。
a. 体外衝撃波結石破砕術
b. 膀胱尿管新吻合術
c. 膀胱拡大術
d. 腎盂形成術
e. 自己導尿